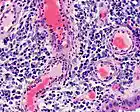
Picture for song 'Chronic-Tech' by artist 'Hoodini'

Hoodini
Filter

Heat Holdaz Heat Holdaz
Midas aka dread + Hoodini Freestyle to Mana-Tech Instrumental. Midas's voice fades out a bit at last half of verse.

Rune Free Rune Free
Midas/C. Heairston first, then JSE/J. Scott Freestyle Rap Mida I know you wrote some of your sh***! lol







Lethal Lethal

Rune2 Rune2


Mana-Tech Mana-Tech

Mysticism Mysticism

Escape Escape

In your Face In your Face

Survival Survival
Chronic-Tech Chronic-Tech


Onyx Onyx
